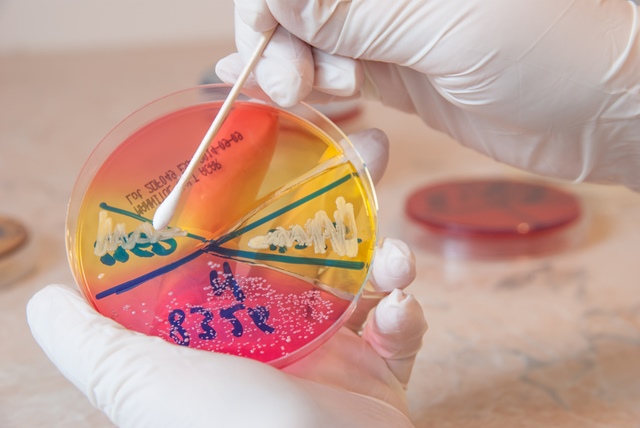

Золотистий стафілокок - які захворювання можуть бути причиною і як від нього позбутися
Staphylococcus aureus, назва походить від латинського staphylococcus aureus, є однією з бактерій, яка викликає більше захворювань в організмі людини. Ця бактерія викликає інфекції в різних областях тіла.
Стафілокок часто зустрічається в шкірі або слизовій оболонці носа у здорових людей і не викликає серйозних проблем. Але інфекції, спричинені золотавим стафілококом, можуть мати серйозні наслідки, якщо бактерії попадають у систему кровообігу, кісткову систему або потрапляють в легені, серці або суглоби.
Лікування включає антибіотики і дренування інфікованої області, але деякі стафілококові інфекції не реагують на звичайні антибіотики.
Причини золотистого стафілокока
Багато людей носять золотий стафілокок, але ніколи не хворіють інфекцією.
Ця бактерія заразна і легко передається при дотику до людини, що носить золотий стафілокок. Як правило, шкіра виступає в якості захисного бар'єру від інфекції, але при наявності шкірних поразок стафілокок може легко проникати в тканини кров, викликаючи інфекції. Гоління рушників або постільної білизни разом з інфікованою людиною сприяє зараженню золотавим стафілококом.
Staphylococcus aureus виживає при екстремальних температурах, лікує шлункову кислоту і навіть фізіологічний розчин.
Люди з ослабленою імунною системою піддаються підвищеному ризику зараження золотими стафілококами.
Симптоми золотистого стафілокока
Золотий стафілокок проявляється по-різному, в залежності від стану, яке він викликає.
Більшість інфекцій, спричинених золотистим стафілококом, відбувається в шкірі або м'яких тканинах.
Шкірні стафілококові інфекції, спричинені золотавим стафілококом:
Шкірний абсцес - проявляється в появі мешочкового мішечка на рівні шкіри, який утворюється або у волосяному фолікулі, або в себорейної залозі. Це проявляється наступними симптомами: запалення шкіри, поява гнійного мішечка в середині запалення і біль.
Импедиго - хворобливе і заразне подразнення шкіри, импедиго проявляється в появі наповнених рідиною основ, колір яких схожий на мед.
Стафілококовий синдром непрозорою шкіри - Золоті стафілококові інфекції продукують певні токсини, які запускають цей синдром, особливо серед немовлят і дітей. Лихоманка, роздратування і шкірні покриви є найбільш поширеними симптомами цього синдрому.
Інші інфекції, спричинені золотавим стафілококом:
Харчове отруєння - золотистий стафілокок є однією з найбільш поширених причин харчового отруєння.Симптоми з'являються швидко, через кілька годин після вживання забрудненої їжі, але вони зникають так само швидко, менше ніж за півдня. Симптоми: нудота, блювання, діарея, зневоднення, низький кров'яний тиск.
Сепсис. Сепсис - это инфекция крови, которая может быть вызвана проникновением золотистого стафилококка в кровь. В случае сепсиса бактерии могут вызывать инфекции во внутренних органах, костях, мышцах или устройствах, имплантированных хирургическим путем. Лихорадка и низкое кровяное давление являются симптомами, характерными для сепсиса.
Синдром токсического шока - это потенциально смертельное состояние может быть вызвано токсинами, продуцируемыми стафилококковыми бактериями, и обычно возникает после операции. Это проявляется: тошнота, рвота, раздражение ладоней, спутанность сознания, мышечные боли, диарея и боли в животе.
Септический артрит - золотистый стафилококк также может вызывать септический артрит, состояние, которое обычно поражает ваши колени, плечи, бедра или пальцы на руках и ногах. Симптомы этого состояния включают воспаление суставов, сильную боль в суставах и лихорадку.
Золотистый стафилококк
После физического осмотра и лабораторного анализа образца ткани, взятого у пациента, врач установит диагноз.
После постановки диагноза врач порекомендует лечение, основанное на антибиотиках и дренаже.
Поскольку золотистый стафилококк может быстро развить устойчивость к определенным антибиотикам, врач может изменить лечение.
Профилактика заражения золотистым стафилококком
Вы можете снизить риск заражения золотыми стафилококками, следуя следующим правилам:
- мойте руки как можно чаще
- прикрыть открытые раны от кожи
- часто меняйте повязки, если у вас перевязанные раны
- Не використовуйте предмети інтимної гігієни разом
- прати білизну і білизна при високих температурах
- Трав'яні засоби від синдрому подразненого кишечникаhttps://doc.ro/sanatate/remedii-naturiste-pentru-sindromul-de-colon-iritabilЧитати статтю
